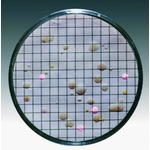
Apri questo segmento con un click

-
- Biochemicals
- Genomics
- Proteomics
- Immunology
- Cell culture
-
Microbiology
- Reagents for microbiology
- Dehydrated culture media
- Ready to use culture media
- Basic materials and supplements
- Microbiology (Cultivation)
- Microbiology Petri dishes
- Sterilizers and burners
- Virus and phage culture
- Cell disruption
- Analysis (Microbiology)
- ATP detection
- Hygiene monitoring
- Rapid tests (Microbiology)
- Bacterial strains
- Histology
- Other life science consumables
- Other life science equipment
Reagents for microbiology
Membrana con tamponi e terreni disidratati

Pad nutriente con terreno di coltura disidratato, sterile su filtro a membrana, in capsula di petri. Confezione sterile singola. Dopo l"idratazione con 3.0/3.5 ml di acqua sterile e mineralizzata (o distillata) sono pronti all"uso. Durata di conservazione in magazzino a partire dalla data di produzione, 18 - 24 mesi, a temperatura ambiente, in base al tipo. Altri terreni di coltura a richiesta....
Microbiological culture media in tubes
Culture media for the detection of microorganisms. Suitable for membrane filtration or direct incubation. The content of a 20 ml tube can be poured into two 90 mm or three 60 mm Petri dishes....
Terreni disidratati
Terreni di coltura disidratati, sterili, in capsule di petri. Dopo l"idratazione con 3,0/3,5 ml di acqua sterile e demineralizzata (o distillata) sono immediatamente pronti all"uso. Tutti i terreni sono forniti con gli appropriati filtri a membrana, che sono anche in confezione individuale sterile. Durata di conservazione del terreno 18 - 24 mesi a temperatura ambiente....
ANTIFOAM A CONCENTRATE
Sigma-Aldrich
PO number | Dimensioni imballaggio | Prezzo per imballaggio | |||
---|---|---|---|---|---|
A5633-25G Nel nostro assortimento questo articolo corrisponde alla sua ricerca. |
25 g | Login / Registrazione |
|
||
A5633-100G Nel nostro assortimento questo articolo corrisponde alla sua ricerca. |
100 g | Login / Registrazione |
|
INDOLE KOVÁCS INDOL REAGENT BACTIDENT
Merck

PO number | Dimensioni imballaggio | Prezzo per imballaggio | |||
---|---|---|---|---|---|
1.11350.0001 Nel nostro assortimento questo articolo corrisponde alla sua ricerca. |
30 ml | Login / Registrazione |
|
Acetaldehyde Assay Kit
Neogen

PO number | Dimensioni imballaggio | Prezzo per imballaggio | |||
---|---|---|---|---|---|
K-ACHYD Nel nostro assortimento questo articolo corrisponde alla sua ricerca. |
1 piece | Login / Registrazione |
|
ACETAMID solution
sifin

PO number | Dimensioni imballaggio | Prezzo per imballaggio | |||
---|---|---|---|---|---|
TN1512-01 Nel nostro assortimento questo articolo corrisponde alla sua ricerca. |
100 x 5ml | Login / Registrazione |
|
Alkaline Peptone Water for microbiology GranuCult® plus
Merck
PO number | Dimensioni imballaggio | Prezzo per imballaggio | |||
---|---|---|---|---|---|
1.01800.0500 Nel nostro assortimento questo articolo corrisponde alla sua ricerca. |
500 g | Login / Registrazione |
|